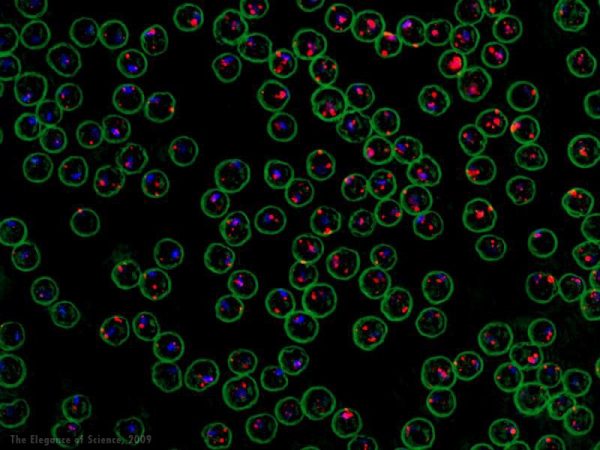
red blood cells

The Elegance of Science 2009
1st Place: Mycorrhizas in Full Color – Megan M. Smith
2nd Place: Orderly destruction – Hannah Vander Zanden
3rd Place: Fatal attraction: when the immune system goes bad – Yaima Luzardo, Clayton E. Mathews, & Molecular Pathology Core
Alumni Award: Lightning Over the Rappahannock – Alumni Award
Honorable Mention: Fullerenes – Victor V. Albert
Mycorrhizas in Full Color, Megan M. Smith
Orderly Destruction, Hannah Vander Zanden
Fatal Attraction, Yaima Luzardo, Clayton E. Mathews, & Molecular Pathology Core
Lightning Over the Rappahannock, Wes Marston
The Roads of Graphene, Victor V. Albert
The Brain Revealed, Adam Mecca
Two of Spades, Amy Washuta
Scorpion, Anastasia Kozak
Ammonite, Anastasia Kozak
The Snail, Anastasia Kozak
The Feast, Anastasia Kozak
Albino Alligator, Anastasia Kozak
Between Life and Death, Andrei Sourakov
Alien Attack, Andrei Sourakov
A Black Hole in the Butterfly Wing, Andrei Sourakov
Butterfly-Brain-Butterfly-Brain, Andrei Sourakov
Orchid Bees, Andrei Sourakov
Nature's Breadcrumbs, Ashley Vaniska
Focus, Ashley Vaniska
Condensation, Ashley Vaniska
Common Thread, Ashley Vaniska
Pin-Sized Globe, Ashley Vaniska
Gator Island, Kannan Balasundaram
B3 lysenin multiple fin, Daniel Witter
contCHOH1w lysenin final, Daniel Witter
B1 lysenin fin, Daniel Witter
control H1 B nile red fin, Daniel Witter
cont7WD10 w lysenin DAPI (multiple)1 fin, Daniel Witter
Magnificent Pollen, David M. Jarzen
Cancer Cells on Nanorods, David Lovett
The Neuron's Assistant, Emily Korszen
The Meal of an Insect, Fabiany Herrera
Alien Leaf, Fabiany Herrera
Yellow Fossil Leaf, Fabiany Herrera
Buoyant Fruit, Fabiany Herrera
Exceptional Flower, Fabiany Herrera
Gradients in Space, Fady Paul Marji
Faces of Second China, Paul Fishwick, Ryan Tanay, Hyungwook Park, Julie Henderson, Rasha Kamhawi, & Amy Jo Coffey
Ms-GFAG2-3, Gerry Shaw
Neuron-Small, Gerry Shaw
5C11-NF-H, Gerry Shaw
Chk-NF-m-2000, Gerry Shaw
Rab-CoroA2 reg-Chi-Vim(4109) -G-2, Gerry Shaw
Life is Nitrogen, Hamilton Jones
Blushing Bromeliad, Hannah Vander Zanden
Beach Morning Glory, Hannah Vander Zanden
Driftwood, Hannah Vander Zanden
Sea Grape, Hannah Vander Zanden
Glowing Edge, Harald Messer
Flagella RYB, Harald Messer
Flagella Blue, Harald Messer
Spherical Chaos, Hung-Yen Lee
Lacewing Eggs, Ijy Chen
A Dewed Flower, Iju Chen
Anthers of Rhododendron, Iju Chen
Ready To Jump!, Iju Chen
Fossil Pollen, Iju Chen
(1+0.4i)sin(z) iterated, Jason Harrington
The Floral Stork, Jis Joseph
Gator Ghost, Jis Joseph
Fungal Steps, Jis Joseph
Web of Gold, Jis Joseph
Aberration, Joanna Scian
EEG Time-Frequency Plot for English Speakers Listening to Thai Lexical Tones, Edith Kaan, Walid Kara, & Andreas Keil
Pyrodinium bahamense, Karen Kelley
Histology Is Where the Heart Is..., Kelley Durden
Protein Christmas Wreath, Kit Fuhrman
Sea Anemone, Machel Malay
Red Blood Cells, Maria Christina Vasquez
Damselfly Catches Glimpse of Running Clubmoss, Mirelle Majas
Striped Horse Fly Makes Out Prickly Pine, Mirelle Majas
Hanging-Thief Robber Fly Detects Hyacinth, Mirelle Majas
Muscle Rivers, Molly Womack
Tissue Whirlpool, Molly Womack
Mutualism, Molly Womack
Muscle Rapids, Molly Womack
Enclosure, Molly Womack
Beauty of Fossilized Wood, Nareerat Boonchai
Nature’s Plate, Nareerat Boonchai
New Summer Life, Nareerat Boonchai
Crystals of a Breast Cancer Drug, David Ostrov, Arieann DeFazio, & Shun Lu
Crystals of a Breast Cancer Drug, David Ostrov, Arieann DeFazio, & Shun Lu
Crystals of a Breast Cancer Drug, David Ostrov, Arieann DeFazio, & Shun Lu
Crystals of a Breast Cancer Drug, David Ostrov, Arieann DeFazio, & Shun Lu
Crystals of a Breast Cancer Drug, David Ostrov, Arieann DeFazio, & Shun Lu
Kidney Sand Dollar, Pedro E Cruz
Solving the Mystery of Flapping Flight, Pin Wu
Looking Past, Sarah Saavedra
Vibrant Neural Chimera, Sue Semple-Rowland, William Coggin, Rachel Ludlow
PML Protein in the Laboratory: 1st step, Sheryl
Interactions, Sheryl Chocron
In Depth, Sheryl Chocron
It's Great to BEE a Florida Gator, Steve McClellan
Between the Layers, Victor V. Albert
Fullerene Fragmentation, Victor V. Albert
The Beauty in Lasers, Yan Chen
An Eye for Excellence // Mouse Eye 5, Zachary Cohen
An Eye for Excellence // Mouse Eye 1, Zachary Cohen
An Eye for Excellence // Mouse Eye 2, Zachary Cohen
An Eye for Excellence // Mouse Eye 4, Zachary Cohen
An Eye for Excellence // Mouse Eye 3, Zachary Cohen
Interleukin 8 Flower, Arieann DeFazio
Interleukin 8 diffraction, Arieann DeFazio
Interleukin 8 abstract, Arieann DeFazio
Colony, Heather Wamsley
A Padlock Hunts for Hidden Infection, Heather Wamsley
Red Fire River Seen from Above, Heather Wamsley
Filamentous Creation, Dana Catalfamo
Osteoclast's Garden in the Light, Dana Catalfamo